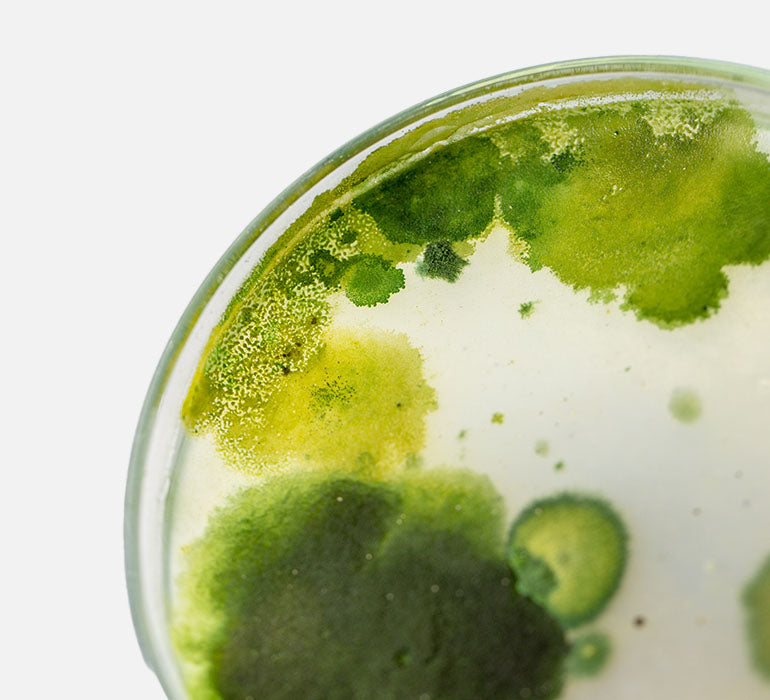

Potential Microalgae Products:
Serums
Moisturizers
Body Lotions
Frequently Asked Questions
How does the ingredient work?
Microalgae is rich in vitamins, minerals, antioxidants, and other beneficial compounds.
Is the ingredient safe for my skin?
Microalgae is generally safe for most skin types.
Are there any side effects?
Some potential side effects include: Allergic Reactions, Itching, Redness.
Is this ingredient derived naturally or chemically?
Microalgae is a natural ingredient. It is a type of plant that is microscopic in size and grows in water.
Still Have Questions?
Send us a quick message below and we will be happy to assist you.
